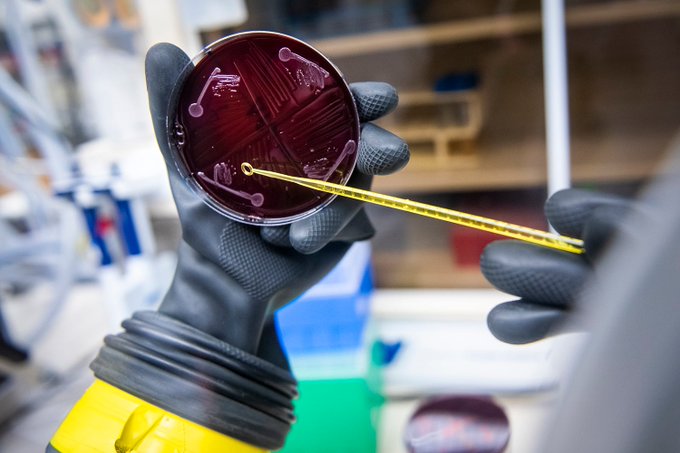
Stanford researchers construct most complex, complete synthetic #microbiome
tinyurl.com/4umuerr2
#precisionhealth

DayTwo
@daytwohealth
DayTwo offers a sustainable path to remission for metabolic disease (diabetes, prediabetes, and clinical obesity).
ID: 715252995336888320
http://www.daytwo.com 30-03-2016 19:02:57
434 Tweet
1,1K Followers
118 Following





We were privileged to have #HBS do a case study of DayTwo in 2018. A lot has changed in 4 years. On Monday, Amir Golan, our Chief of Biz Dev was at Harvard Business School to discuss our journey and lessons learned. tinyurl.com/26cjwv6c #healthcare #precisionhealth #microbiome #t2d



1⃣more day until our next #GoLive Webinar: Healthy is Hard - Creating Equitable Health Benefits for Women on 8/4 at 1pm ET! featuring: Vitality USA MassGeneral News Moderna Benefit Bump Add to your 📅now: tinyurl.com/2p9evsvz



What is known on the role of gut microbiome in multiple sclerosis? This review in Nat Rev Neurology updates emerging studies on probiotics, short-chain fatty acids and faecal microbial transplantation for the treatment of this condition ow.ly/ug8c30spxOh






Why a workout is good for your gut bacteria tinyurl.com/46dktvzd via BBC Future #gutmicrobiome